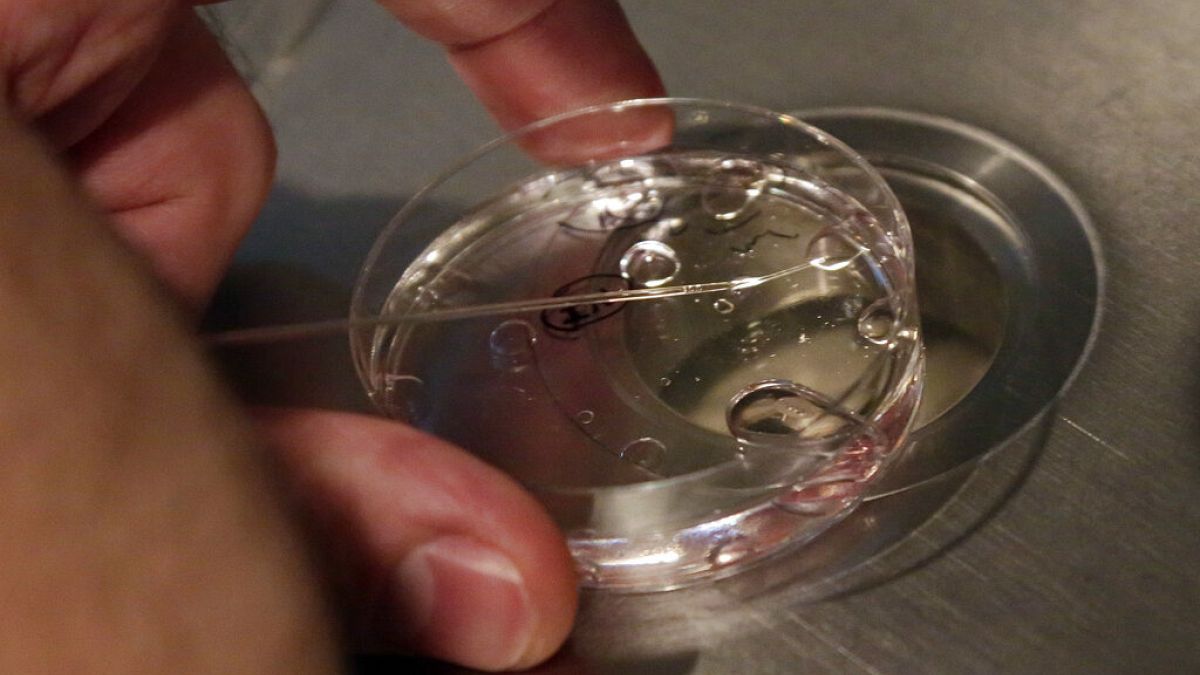
Poland welcomes first child born after IVF policy change.

En 2024, le gouvernement polonais a annulé une décision de 2015 de réduire le financement public pour le traitement de la FIV. Le premier bébé est né à la suite du changement de politique mercredi.
Un enfant conçu par Fertilization in vitro (FIV) est né mercredi en Pologne, le premier depuis que le président Andrzej Duda a signé un projet de loi qui a rétabli le financement public pour le traitement de la fertilité.
Le financement a déjà été réduit par l’ancien gouvernement conservateur en 2015.
Le ministère de la Santé a annoncé la naissance dans un post sur X, déclarant que « la première fille est née à la suite du programme de FIV du gouvernement », ajoutant que « cette naissance est un moment extraordinaire qui est la preuve du progrès et de la prise en charge de la santé des familles. »
Le Premier ministre polonais Donald Tusk a également fait remarquer la naissance de la jeune fille dans une vidéo publiée sur X. « Nous l’attendons tous, pas seulement les parents heureux », a-t-il dit, ajoutant que « leur joie sera un bon signe (… ) pour tous les autres couples. »
La décision du président Duda de signer le projet de loi en fournissant un financement public pour la FIV l’année dernière a rencontré la résistance des conservateurs polonais, notamment le chef de l’Église catholique de la Pologne, qui a tenté de bloquer le projet de loi, faisant référence à la FIV comme « expérimentation sur l’homme ».
Cependant, le bureau de Duda, dont l’ancien parti est le droit et la justice conservateurs et catholiques (PIS), l’a décrit comme une solution potentielle aux « défis démographiques » de la Pologne, car la Pologne a vu son taux de natalité diminuer ces dernières années.
Dans une interview avec le diffuseur polonais Tok FM, le ministre polonais de la Santé Izabela Leszczyzna a annoncé des données spécifiques relatives aux impacts du financement de la FIV, déclarant que plus de 23 000 couples se sont qualifiés pour le traitement de la FIV et 9 258 femmes sont tombées enceintes.